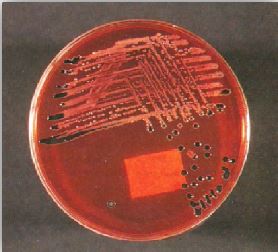

النبات

مواضيع عامة في علم النبات

الجذور - السيقان - الأوراق

النباتات الوعائية واللاوعائية

البذور (مغطاة البذور - عاريات البذور)

الطحالب

النباتات الطبية


الحيوان

مواضيع عامة في علم الحيوان

علم التشريح

التنوع الإحيائي

البايلوجيا الخلوية


الأحياء المجهرية

البكتيريا

الفطريات

الطفيليات

الفايروسات


علم الأمراض

الاورام

الامراض الوراثية

الامراض المناعية

الامراض المدارية

اضطرابات الدورة الدموية

مواضيع عامة في علم الامراض

الحشرات


التقانة الإحيائية

مواضيع عامة في التقانة الإحيائية


التقنية الحيوية المكروبية

التقنية الحيوية والميكروبات

الفعاليات الحيوية

وراثة الاحياء المجهرية

تصنيف الاحياء المجهرية

الاحياء المجهرية في الطبيعة

أيض الاجهاد

التقنية الحيوية والبيئة

التقنية الحيوية والطب

التقنية الحيوية والزراعة

التقنية الحيوية والصناعة

التقنية الحيوية والطاقة

البحار والطحالب الصغيرة

عزل البروتين

هندسة الجينات


التقنية الحياتية النانوية

مفاهيم التقنية الحيوية النانوية

التراكيب النانوية والمجاهر المستخدمة في رؤيتها

تصنيع وتخليق المواد النانوية

تطبيقات التقنية النانوية والحيوية النانوية

الرقائق والمتحسسات الحيوية

المصفوفات المجهرية وحاسوب الدنا

اللقاحات

البيئة والتلوث


علم الأجنة

اعضاء التكاثر وتشكل الاعراس

الاخصاب

التشطر

العصيبة وتشكل الجسيدات

تشكل اللواحق الجنينية

تكون المعيدة وظهور الطبقات الجنينية

مقدمة لعلم الاجنة


الأحياء الجزيئي

مواضيع عامة في الاحياء الجزيئي


علم وظائف الأعضاء


الغدد

مواضيع عامة في الغدد

الغدد الصم و هرموناتها

الجسم تحت السريري

الغدة النخامية

الغدة الكظرية

الغدة التناسلية

الغدة الدرقية والجار الدرقية

الغدة البنكرياسية

الغدة الصنوبرية

مواضيع عامة في علم وظائف الاعضاء

الخلية الحيوانية

الجهاز العصبي

أعضاء الحس

الجهاز العضلي

السوائل الجسمية

الجهاز الدوري والليمف

الجهاز التنفسي

الجهاز الهضمي

الجهاز البولي


المضادات الميكروبية

مواضيع عامة في المضادات الميكروبية

مضادات البكتيريا

مضادات الفطريات

مضادات الطفيليات

مضادات الفايروسات

علم الخلية

الوراثة

الأحياء العامة

المناعة

التحليلات المرضية

الكيمياء الحيوية

مواضيع متنوعة أخرى

الانزيمات
الحالات المرضية البكتيرية :الحالة الخامسة والعشرون
المؤلف:
عبد الرزاق سليمان التومي ، محمد محمد الامام ، عبد الباسط رمضان
المصدر:
اساسيات التشخيص البكتريولوجي المعملي والسريري
الجزء والصفحة:
4-9-2016
1793
الحالات المرضية البكتيرية :الحالة الخامسة والعشرون
بعد فترة وجيزة من عودته من أفريقيا بدأت صحة هذا المريض في التدهور وعاني من سعال وارتفاع في درجة الحرارة مع إمساك بعد ذلك ازدادت حالته الصحية سواءاً بعد عدة أيام وأصبح يعاني من إسهال، بالكشف عليه تبين وجود طفح جلدي وتضخم الطحال. عدد كريات الدم البيضاء 4.0 X 109 / لتر ، تم زراعة عينة من الدم على الوسط الغذائي المناسب كما في الشكل 1 كما زرعت عينة من البراز على الوسط الغذائي المناسب كما في الشكل رقم 2 .

الشكل رقم 1 : الفحص المجهري
الشكل رقم 2 : المزرعة البكتيرية
الأسئلة :
1- ما تشخيصك التقديري لهذه الحالة ؟
2- كيف يمكنك التأكد من هذا التشخيص بالاختبارات الجرثومية ؟
3- كيف تتم معالجة هذا المريض؟
الإجابة :
1- حالة هذا المريض تعرف بحمى التيفود typhoid fever وتستغرق فترة الحضانة حوالي 14-10 يوم ، ومن صفات هذا المريض ان الشخص المصاب يعاني في البداية من إمساك ثم سرعان ما يتحول إلى إسهال إذا لم يعالج المريض ومن العلامات التي تساعد على التشخيص السريري للحالة هو تكون ما يعرف بالبقع الوردية rose spots على الصدر والأكتاف وكذلك تضخم الطحال ونقص في كريات الدم البيضاء. يعتبر النوع البكتيري Salmonella typhi المسبب الرئيسي لهذه الحالة وهذه البكتيريا تنتقل عن طريق الماء الملوث بالفضلات الآدمية وبالتالي فإن الماء يلعب دوراً مباشراً في إحداث المرض أو غير مباشراً وذلك عند استعماله في غسيل الخضراوات وما شابه ذلك وبعد ابتلاع هذه البكتيريا تبدأ في دخول الطور الابتدائي الموضعي وهو التكاثر داخل خلايا النسيج الليمفاوي للأمعاء الدقيقة ثم يعقبه وصول البكتيريا للدم bacteraemic phase وهو الطور الثاني وتواصل التكاثر فندخل الطور التالي وهو طور تجرثم الدم septicaemic phase فنبدأ البكتيريا في الانتشار داخل الجسم لتصل لأعضاء مختلفة من الجسم فقط يصاب المريض بمرض التهاب السحايا أو التهاب الرئة أو التهاب العظام وأمراض اخرى. وإن تواصل يجب إبلاغ السلطات المختصة بالأمراض السارية حول الحالات التي يتم تشخيصها.
2- غالباً ما يتم عزل هذه البكتيريا في الأسبوع الثاني أو الثالث من حدوث المرض بزراعة عينة من الدم كما يمكن زراعة عينة من البول أو البراز ، وكذلك يمكننا عزلها من عينة البصاق وسائل النخاع الشوكي ويتم استعمال الوسط الغذائي التفريقي DCA أو XLD وفي وسط غذائي مغذي وهو حساء Selenite F broth بعد مضي فترة التضحين تظهر مستعمرات باهتة اللون (نتيجة لعدم قدرتها على تخمير سكر اللاكتوز) وقد تظهر سوداء اللون نتيجة لتكون المركب كبريتات الهيدروجين hydrogen sulhide كما في الشكل رقم 2.25. وبعد ذلك يتم إجراء الاختبارات الكيموحيةي والمصلية للتأكد من التعريف. وهذا المرض قد يسببه النوع البكتيري S. paratyphi من النوع A ، B أو النوع C بالإضافة للنوع البكتيري S. typhi كما أنه ناذراً ما يكون ناتجاً من الإصابة بالنوع البكتيري S. choleraesuis .
كما يتم إجراء اختبار وابدال Widal test للكشف عن الأجسام المضادة للنوع البكتيري S. typhi والنوع البكتيري S. paratyphi في مصل المريض. وهذا الاختبار ليس له أهمية كبيرة في التشخيص.
3- يعتبر المضاد الحيوي Ciproloxacin العلاج الفعال لبعض الحالات كما يمكن استعمال المضاد الحيوي chloramphenicol كعلاج بديل مع أن فعاليته محدودة في بعض المناطق لانتشار السلالات المقاومة لهذا المضاد كما يمكن استعمال المضاد الحيوي co-trimoxazole أو المضاد الحيوي ampicillin .
الاكثر قراءة في البكتيريا
اخر الاخبار
اخبار العتبة العباسية المقدسة
الآخبار الصحية

قسم الشؤون الفكرية يصدر كتاباً يوثق تاريخ السدانة في العتبة العباسية المقدسة
"المهمة".. إصدار قصصي يوثّق القصص الفائزة في مسابقة فتوى الدفاع المقدسة للقصة القصيرة
(نوافذ).. إصدار أدبي يوثق القصص الفائزة في مسابقة الإمام العسكري (عليه السلام)